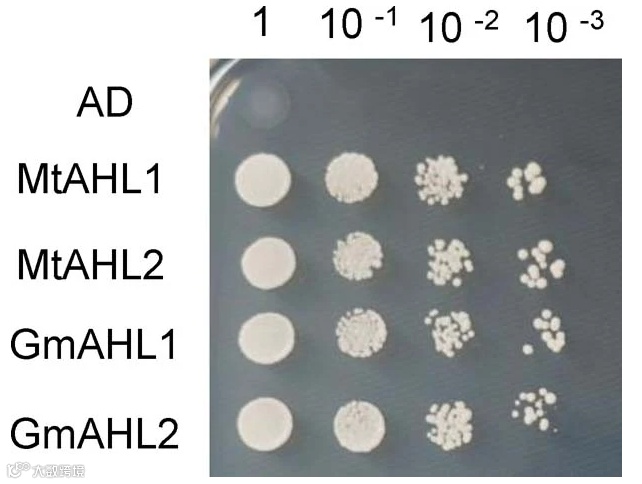

众所周知,转录因子结合在基因启动子区域调控基因的表达,是基因表达量改变最重要的调控方式。那转录因子与靶基因之间的对应关系便成为研究的重点。当我们的研究锁定了靶基因,但是不知道是哪些转录因子参与了调控的时候该如何研究呢?之前的文章给大家介绍过《启动子的查找以及转录因子结合位点预测》,今天我们来介绍一下如何通过实验手段找到靶基因上游的转录因子——以DNA为中心的互作检测手段。
DNA pull down 技术是体外研究DNA 与蛋白质互作的有力工具。该技术针对目标区域设计特异性DNA 探针并经过脱硫生物素标记,脱硫生物素探针可以和偶联在磁珠上的链霉亲和素亲和结合。然后,细胞核提取物与磁珠-DNA 探针孵育,作用蛋白质分子可以和DNA 探针特异性结合;经过洗涤可以将非特异性结合蛋白质去除;最后,经洗脱液洗脱,得到目的DNA 探针-蛋白质复合物,再经过Western Blot 或质谱(MS)鉴定蛋白质类型。其原理图:

DNA pulldown原理图
对于研究的启动子靶标区域没具体预测区域,一般针对基因上游2000bp序列设计引物,并标记上生物素作为DNA pull down的探针。
Yeast One Hybrid(酵母单杂交)技术最早是从酵母双杂交技术发展而来,通过对报告基因的表型检测,分析DNA与蛋白之间的相互作用,以研究真核细胞内的基因表达调控。
真核生物基因的转录起始需转录因子参与,转录因子通常由一个DNA特异性结合功能域和一个或多个其他调控蛋白相互作用的激活功能域组成,即DNA结合结构域(DNA-bindingdomain BD)和转录激活结构域(activationdomain,AD)。用于酵母单杂交系统的酵母GAL4蛋白是一种典型的转录因子,GAL4的DNA结合结构域靠近羟基端,含有几个锌指结构,可激活酵母半乳糖苷酶的上游激活位点(UGS),而转录激活结构域可与RNA聚合酶或转录因子TFIID相互作用,提高RNA聚合酶的活性。在这一过程中,DNA结合结构域和转录激活结构域可完全独立地发挥作用。据此,我们可以将GAL4的DNA结合结构域置换为转录因子编码基因,将顺式作用元件与基本启动子(minimal promoter, Pmin)和报告基因连接。只要转录因子能与目的DNA元件相互作用,即可通过转录激活结构域激活RNA聚合酶,启动子下游报告基因的转录。原理图:

/ |
酵母单杂交 |
DNA pulldown |
|
|
a. 高通量:可以同时筛选大量可能的相互作用蛋白,提高发现新靶点的几率。
b. 直接检测:可以直接检测转录因子与DNA序列的相互作用,无需进行复杂的蛋白质提纯过程。
|
a. 高灵敏度:可以检测到低丰度的相互作用蛋白,提高实验的灵敏度。 b. 高特异性:通过使用生物素标记的DNA探针,可以特异性地富集与目标基因相互作用的蛋白。 c. 适用于复杂样品:适用于从复杂样品中筛选目标蛋白,如细胞裂解液、组织匀浆等。 |
|
|
a. 假阳性率较高:由于酵母表达系统可能存在非特异性结合,可能导致假阳性结果的出现。 b. 依赖于已知的转录因子:该方法依赖于已知的转录因子,对于新发现的基因可能无法找到相应的转录因子。 c. 低灵敏度:相对于其他方法,酵母单杂交筛库的灵敏度较低,可能导致一些弱相互作用无法被检测到。 |
a. 依赖于DNA探针设计:该方法依赖于DNA探针的设计,可能存在探针特异性不足的问题。 b. 蛋白质丰度限制:高丰度的蛋白质可能更容易被检测到,而低丰度的蛋白质可能被忽略。 c. 需要额外的样品处理:相对于酵母单杂交筛库,DNA pulldown需要额外的样品处理步骤,如蛋白酶K处理、RNAase处理等,操作相对繁琐。 |
根瘤菌在豆科植物根瘤细胞内的共生固氮作用减轻了对氮肥的需求。固氮过程需要内共生菌分化为可逆或终端的类菌体。后者受植物控制,更有益且已在豆科植物的多个类群中演化。倒置重复缺失类群豆科植物(IRLC)的植物效应子是根瘤特异性富含半胱氨酸(NCR)肽,而在像大豆这样的非终端分化豆科植物中不存在。先前认为NCRs与特定转录因子共同演化,但作者的研究表明NCR基因的表达并不需要NCR特异性转录因子。将苜蓿的NCR169基因在其自身启动子的驱动下引入大豆根部,结果在根瘤中特异性表达,导致与终端分化相关的细菌体变化。研究者们利用酵母单杂交和DNA pull down鉴定出了来自苜蓿和大豆根瘤的两个AT-Hook Motif Nuclear Localized(AHL)转录因子,它们能够结合NCR169启动子中的AT丰富序列,诱导其表达。虽然NCR169的突变在晚期阶段阻止了类菌体发育,但MtAHL1或MtAHL2的缺失完全阻止了类菌体分化,表明它们还调节其他NCR基因,这些基因对于氮固定根瘤的发育至关重要。在非-IRLC豆科植物中,同源转录因子对NCRs的调节为提高缺乏NCRs的豆科植物的氮固定效率提供了可能性。

在Y1H文库筛选(1181 bp)和DNA pulldown(382 bp)中鉴定出的NCR169启动子区相互作用的蛋白质
酵母单杂交(Y1H)检测NCR169 1181bp启动子区域与MtAHL 1、MtAHL2、GmAHL1或GmAHL2的结合

进行性蛋白尿是糖尿病肾病(DN)的早期临床特征之一。在本研究中,研究者们使用了JASPAR数据库和DNA pulldown结合LC-MS来确定DN中DLX6-AS1的潜在调节因子,随后进行的双荧光素酶报告基因分析和染色质免疫沉淀证实了结合位点。此外,研究者们还在db/db小鼠模型和培养的人类足细胞中研究了调节因子对DN进展的影响。通过这些方法的分析,研究者们鉴定出了一些可能的DLX6-AS1调节因子。这些调节因子可能通过与DLX6-AS1的特定结合位点相互作用,影响其表达水平。在db/db小鼠模型和培养的人类足细胞中,这些调节因子对DN的进展产生了影响。总的来说,本研究揭示了DN中DLX6-AS1的一些潜在调节因子,为理解DN的发病机制和寻找治疗靶点提供了新的线索。

转录因子CREB参与了DLX6-AS1的上调

YSL1和YSL3在叶子、花粉和发育中的种子中运输金属-尼古丁胺(NA)复合物,并在调节种子发育和成熟阶段的铁(Fe)积累中起重要作用。然而,它们的基因转录水平如何调节尚不清楚。在这项研究中,研究者使用酵母单杂交筛选鉴定出转录因子WRKY12,它在拟南芥中直接调节YSL1和YSL3基因的转录水平。WRKY12与YSL1和YSL3具有相反的表达模式,wrky12突变体对Fe缺乏具有耐受性,而WRKY12过表达系对Fe缺乏敏感。在种子发育和成熟过程中,WRKY12可以直接结合YSL1和YSL3的启动子并抑制它们的表达。遗传分析表明,WRKY12在种子发育和成熟阶段的Fe摄入中位于YSL1和YSL3的上游。总之,该研究的结果表明,WRKY12通过抑制YSL1和YSL3的表达,负调控植物种子中的铁摄入。

酵母单杂交法筛选YSL1和YSL3调控基因
酵母单杂交和DNA pulldown是两种用于识别目标基因与转录因子相互作用的方法。两种方法各有优缺点,在实际应用中,可以根据实验目的和样品特点选择合适的方法。在某些情况下,可以结合这两种方法以提高结果的准确性和可靠性。
